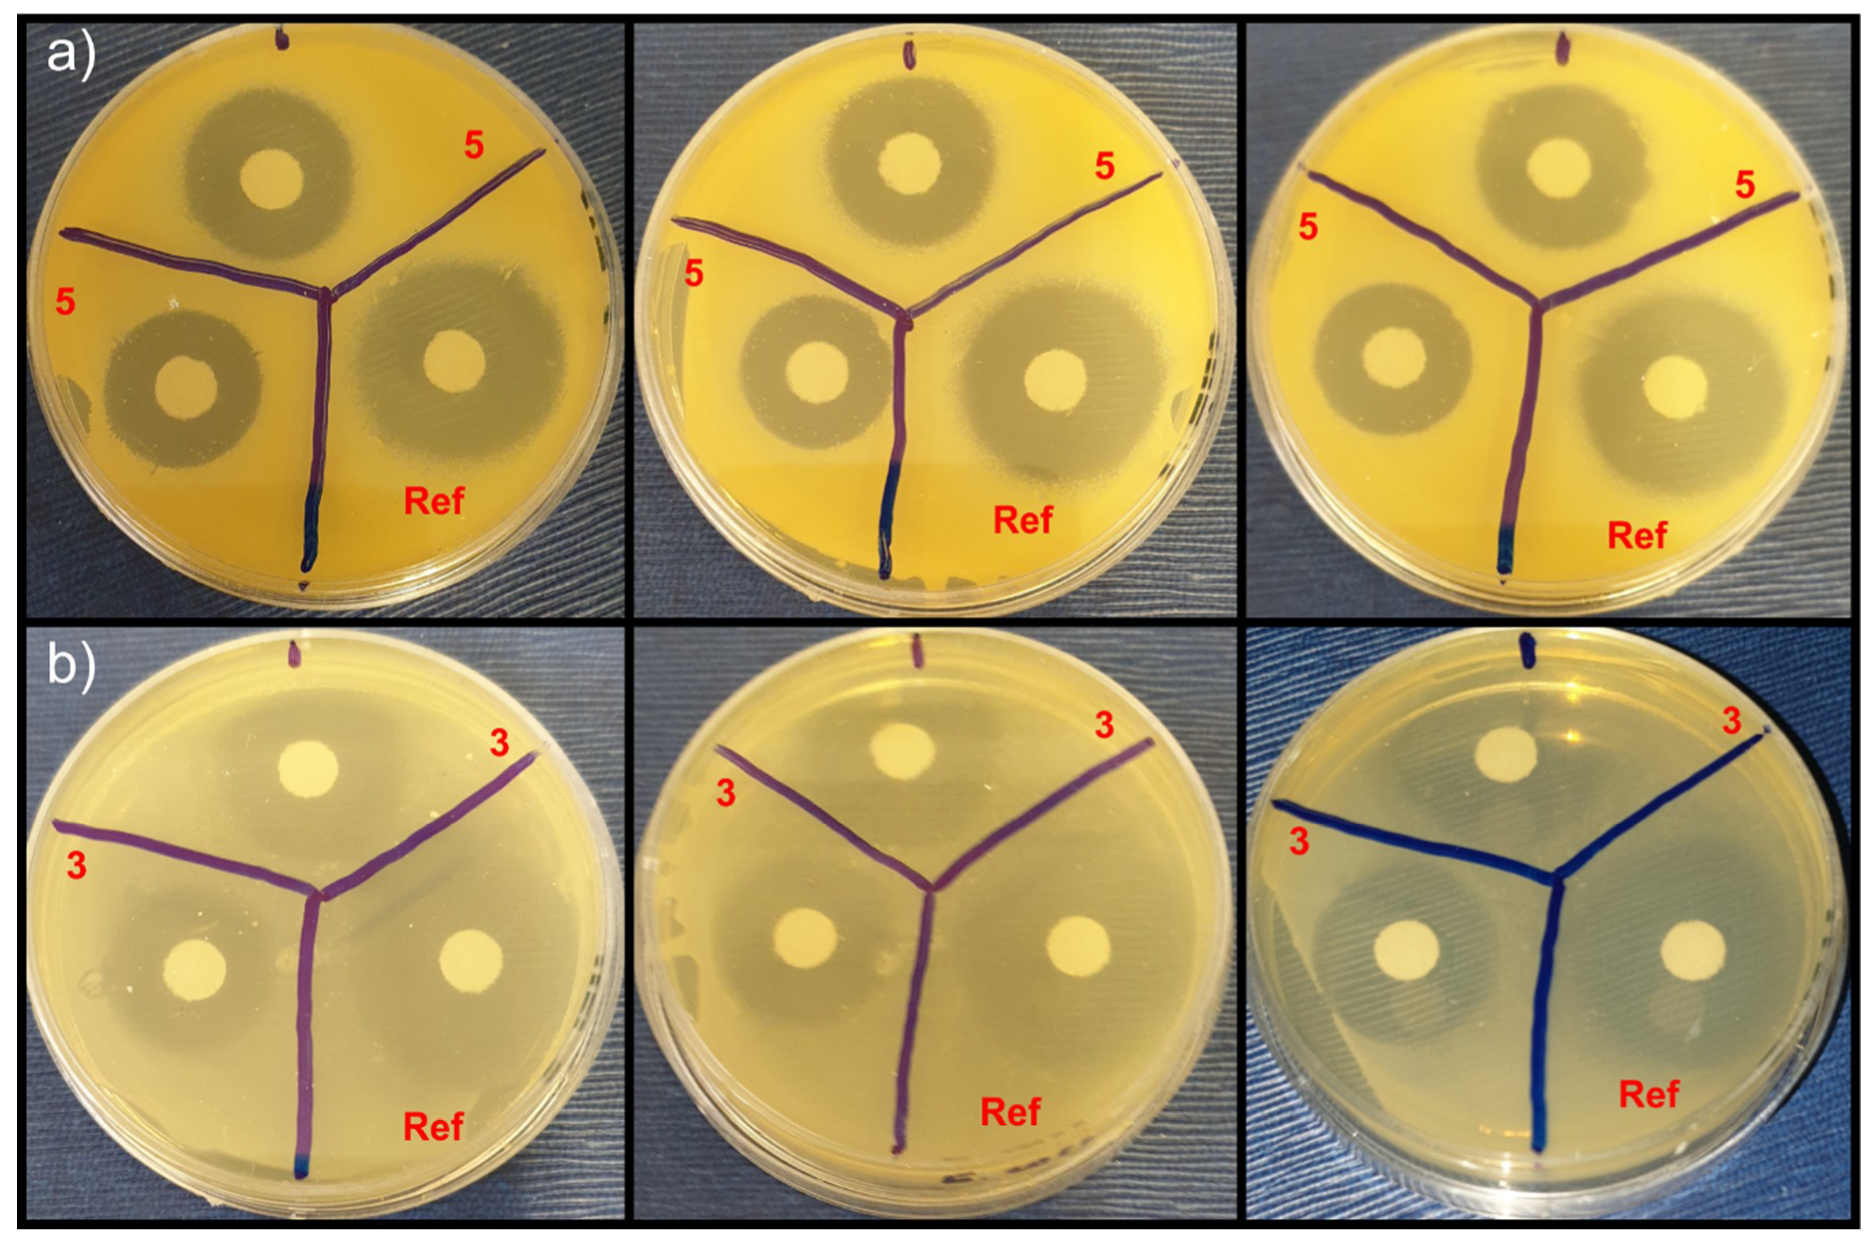
Crystals 10 00339 g004 Crystals 10 00339 g004

Novel Quaternary Ammonium Derivatives of 4-Pyrrolidino Pyridine: Synthesis, Structural, Thermal, and Antibacterial Studies
Abstract
1. Introduction
2. Materials and Methods
2.1. Synthesis and Crystallization
2.1.1. Synthesis of 1-(2-(3-Nitrophenyl)-2-Oxoethyl)-4-(Pyrrolidin-1-yl)Pyridin-1-Ium Bromide, Compound 1
2.1.2. Synthesis of 1-(2-(3,4-Dihydro-2h-Benzo[B][1,4]Dioxepin-7-Yl)-2-Oxoethyl)-4-(Pyrrolidin-1-Yl)Pyridin-1-Ium Bromide, Compound 2
2.1.3. Synthesis of 1-(2-(2,4-Dimethoxyphenyl)-2-Oxoethyl)-4-(Pyrrolidin-1-yl)Pyridin-1-Ium Bromide, Compound 3
2.1.4. Synthesis of 1-(2-Oxo-2-Phenylethyl)-4-(Pyrrolidin-1-yl) Pyridin-1-Ium Bromide, Compound 4
2.1.5. Synthesis of 1-(2-([1,1’-Biphenyl]-4-yl)-2-Oxoethyl)-4-(Pyrrolidin-1-yl) Pyridin-1-Ium Bromide, Compound 5
2.1.6. Synthesis of 1-Butyl-4-(Pyrrolidin-1-yl) Pyridin-1-Ium Iodide, Compound 6
2.2. Characterization Methods
2.2.1. Single Crystal X-ray Diffraction (SCXRD)
2.2.2. Powder X-ray Diffraction (PXRD)
2.2.3. Nuclear Magnetic Resonance (NMR) Spectroscopy
2.2.4. Differential Scanning Calorimetry (DSC)
2.2.5. Disk-Diffusion Method (Kirby-Bauer Test)
3. Results and Discussion
3.1. Single Crystal XRD Studies
3.2. DSC Studies
3.3. Antibacterial Susceptibility Testing and Activity
4. Conclusions
Supplementary Materials
Author Contributions
Funding
Acknowledgments
Conflicts of Interest
References
- Garcia, M.T.; Kaczerewska, O.; Ribosa, I.; Brycki, B.; Materna, P.; Drgas, M. Biodegradability and aquatic toxicity of quaternary ammonium-based gemini surfactants: Effect of the spacer on their ecological properties. Chemosphere 2016, 154, 155–160. [Google Scholar] [CrossRef] [PubMed]
- Shukla, D.; Tyagi, V. Cationic gemini surfactants: A review. J. Oleo Sci. 2006, 55, 381–390. [Google Scholar] [CrossRef]
- Liu, S.; Kumatabara, Y.; Shirakawa, S. Chiral quaternary phosphonium salts as phase-transfer catalysts for environmentally benign asymmetric transformations. Green Chem. 2016, 18, 331–341. [Google Scholar] [CrossRef]
- Kaneko, S.; Kumatabara, Y.; Shirakawa, S. A new generation of chiral phase-transfer catalysts. Org. Biomol. Chem. 2016, 14, 5367–5376. [Google Scholar] [CrossRef]
- Mondal, M.G.; Pratap, A.P. Synthesis and properties of esterquats as antibacterial agent and fabric softener. Tenside Surfactants Deterg. 2017, 54, 78–84. [Google Scholar] [CrossRef]
- Tawfik, S.M. Ionic liquids based gemini cationic surfactants as corrosion inhibitors for carbon steel in hydrochloric acid solution. J. Mol. Liq. 2016, 216, 624–635. [Google Scholar] [CrossRef]
- Marino, M.; Kreuer, K. Alkaline stability of quaternary ammonium cations for alkaline fuel cell membranes and ionic liquids. ChemSusChem 2015, 8, 513–523. [Google Scholar] [CrossRef]
- Liao, J.; Ye, Z. Quaternary ammonium cationic polymer as a superior bifunctional binder for lithium–sulfur batteries and effects of counter anion. Electrochim. Acta 2018, 259, 626–636. [Google Scholar] [CrossRef]
- Kwok, C.Y.; Pang, Q.; Worku, A.F.; Liang, X.; Gauthier, M.; Nazar, L.F. Impact of the mechanical properties of a functionalized cross-linked binder on the longevity of Li-S batteries. Acs Appl. Mater. Interfaces 2019, 11, 22481–22491. [Google Scholar] [CrossRef]
- Tenover, F.C. Mechanisms of antimicrobial resistance in bacteria. Am. J. Med. 2006, 119, S3–S10. [Google Scholar] [CrossRef]
- Tischer, M.; Pradel, G.; Ohlsen, K.; Holzgrabe, U. Quaternary ammonium salts and their antimicrobial potential: Targets or nonspecific interactions? ChemMedChem 2012, 7, 22–31. [Google Scholar] [CrossRef]
- Dunning Hotopp, J.C. Horizontal gene transfer between bacteria and animals. Trends Genet. (Regul. Ed.) 2011, 27, 157–163. [Google Scholar] [CrossRef] [PubMed]
- Livermore, D.M. Bacterial resistance: Origins, epidemiology, and impact. Clin. Infect. Dis. 2003, 36, S11–S23. [Google Scholar] [CrossRef] [PubMed]
- Schindler, B.D.; Kaatz, G.W. Multidrug efflux pumps of gram-positive bacteria. Drug Resist. Updates 2016, 27, 1–13. [Google Scholar] [CrossRef] [PubMed]
- Worthington, R.J.; Melander, C. Overcoming resistance to β-lactam antibiotics. J. Org. Chem. 2013, 78, 4207–4213. [Google Scholar] [CrossRef]
- Buffet-Bataillon, S.; Tattevin, P.; Maillard, J.-Y.; Bonnaure-Mallet, M.; Jolivet-Gougeon, A. Efflux pump induction by quaternary ammonium compounds and fluoroquinolone resistance in bacteria. Future Microbiol. 2016, 11, 81–92. [Google Scholar] [CrossRef]
- Locher, H.H.; Ritz, D.; Pfaff, P.; Gaertner, M.; Knezevic, A.; Sabato, D.; Schroeder, S.; Barbaras, D.; Gademann, K. Dimers of nostocarboline with potent antibacterial activity. Chemotherapy 2010, 56, 318–324. [Google Scholar] [CrossRef]
- Tischer, M.; Sologub, L.; Pradel, G.; Holzgrabe, U. The bisnaphthalimides as new active lead compounds against plasmodium falciparum. Bioorganic Med. Chem. 2010, 18, 2998–3003. [Google Scholar] [CrossRef]
- Ma, M.; Sun, G. Antimicrobial cationic dyes: Part 2—Thermal and hydrolytic stability. Dye. Pigment. 2004, 63, 39–49. [Google Scholar] [CrossRef]
- Kang, C.K.; Kim, S.S.; Kim, S.; Lee, J.; Lee, J.-H.; Roh, C.; Lee, J. Antibacterial cotton fibers treated with silver nanoparticles and quaternary ammonium salts. Carbohydr. Polym. 2016, 151, 1012–1018. [Google Scholar] [CrossRef]
- Liu, G.; Wu, G.; Jin, C.; Kong, Z. Preparation and antimicrobial activity of terpene-based polyurethane coatings with carbamate group-containing quaternary ammonium salts. Prog. Org. Coat. 2015, 80, 150–155. [Google Scholar] [CrossRef]
- Tan, W.; Li, Q.; Dong, F.; Wei, L.; Guo, Z. Synthesis, characterization, and antifungal property of chitosan ammonium salts with halogens. Int. J. Biol. Macromol. 2016, 92, 293–298. [Google Scholar] [CrossRef] [PubMed]
- Wei, L.; Li, Q.; Chen, Y.; Zhang, J.; Mi, Y.; Dong, F.; Lei, C.; Guo, Z. Enhanced antioxidant and antifungal activity of chitosan derivatives bearing 6-o-imidazole-based quaternary ammonium salts. Carbohydr. Polym. 2019, 206, 493–503. [Google Scholar] [CrossRef] [PubMed]
- Zhang, A.; Liu, Q.; Lei, Y.; Hong, S.; Lin, Y. Synthesis and antimicrobial activities of acrylamide polymers containing quaternary ammonium salts on bacteria and phytopathogenic fungi. React. Funct. Polym. 2015, 88, 39–46. [Google Scholar] [CrossRef]
- Conejo-García, A.; Pisani, L.; del Carmen Núnez, M.; Catto, M.; Nicolotti, O.; Leonetti, F.; Campos, J.M.; Gallo, M.A.; Espinosa, A.; Carotti, A. Homodimeric bis-quaternary heterocyclic ammonium salts as potent acetyl-and butyrylcholinesterase inhibitors: A systematic investigation of the influence of linker and cationic heads over affinity and selectivity. J. Med. Chem. 2011, 54, 2627–2645. [Google Scholar] [CrossRef]
- Obligacion, J.V.; Chirik, P.J. Bis (imino) pyridine cobalt-catalyzed alkene isomerization–hydroboration: A strategy for remote hydrofunctionalization with terminal selectivity. J. Am. Chem. Soc. 2013, 135, 19107–19110. [Google Scholar] [CrossRef]
- Dalaigh, C.O.; Hynes, S.J.; O’Brien, J.E.; McCabe, T.; Maher, D.J.; Watson, G.W.; Connon, S.J. Asymmetric acyl-transfer promoted by readily assembled chiral 4-n, n-dialkylaminopyridine derivatives. Org. Biomol. Chem. 2006, 4, 2785–2793. [Google Scholar] [CrossRef]
- Uchida, N.; Kuwabara, J.; Taketoshi, A.; Kanbara, T. Molecular design of organic superbases, azacalix [3](2, 6) pyridines: Catalysts for 1, 2-and 1, 4-additions. J. Org. Chem. 2012, 77, 10631–10637. [Google Scholar] [CrossRef]
- Małecki, J.G.; Maroń, A. Chloride and pseudohalide hydride-carbonyl ruthenium (ii) complexes with 4-pyrrolidinopyridine as co-ligand. Transit. Met. Chem. 2013, 38, 133–142. [Google Scholar] [CrossRef]
- Abboud, J.-L.M.; Notario, R.; Bertrán, J.; Solà, M. One century of physical organic chemistry: The Menshutkin reaction. Prog. Phys. Org. Chem. 1993, 19, 1–182. [Google Scholar]
- Sola, M.; Lledos, A.; Duran, M.; Bertran, J.; Abboud, J.L.M. Analysis of solvent effects on the menshutkin reaction. J. Am. Chem. Soc. 1991, 113, 2873–2879. [Google Scholar] [CrossRef]
- Castejon, H.; Wiberg, K.B. Solvent effects on methyl transfer reactions. 1. The menshutkin reaction. J. Am. Chem. Soc. 1999, 121, 2139–2146. [Google Scholar] [CrossRef]
- Acevedo, O.; Jorgensen, W.L. Exploring solvent effects upon the menshutkin reaction using a polarizable force field. J. Phys. Chem. B 2010, 114, 8425–8430. [Google Scholar] [CrossRef] [PubMed]
- Ropponen, J.; Lahtinen, M.; Busi, S.; Nissinen, M.; Kolehmainen, E.; Rissanen, K. Novel one-pot synthesis of quaternary ammonium halides: New route to ionic liquids. New J. Chem. 2004, 28, 1426–1430. [Google Scholar] [CrossRef]
- Campos, J.N.; del Carmen Núñez, M.A.; Rodrı́guez, V.; Entrena, A.; Hernández-Alcoceba, R.; Fernández, F.; Lacal, J.C.; Gallo, M.A.; Espinosa, A. Lumo energy of model compounds of bispyridinium compounds as an index for the inhibition of choline kinase. Eur. J. Med. Chem. 2001, 36, 215–225. [Google Scholar] [CrossRef]
- Rusew, R.; Kurteva, V.; Shivachev, B. Antibacterial activity of novel quaternary ammonium salts of quinoline and 4-pyrolidino pyridine. Bulg. Chem. Commun. 2018, 50F, 115–125. [Google Scholar]
- Rigaku, O. Crysalis pro; Rigaku Oxford Diffraction: Yarnton, UK, 2015. [Google Scholar]
- Sheldrick, G.M. A short history of shelx. Acta Crystallogr. Sect. A: Found. Crystallogr. 2008, 64, 112–122. [Google Scholar]
- Farrugia, L.J. Ortep-3 for windows-a version of ortep-III with a graphical user interface (GUI). J. Appl. Crystallogr. 1997, 30, 565. [Google Scholar] [CrossRef]
- Schmidt, A.; Mordhorst, T.; Nieger, M. From uncharged to decacationic molecules: Syntheses and spectroscopic properties of heteroarenium-substituted pyridines. Org. Biomol. Chem. 2005, 3, 3788–3793. [Google Scholar] [CrossRef]
- Schmidt, A.; Vainiotalo, P.; Kindermann, M.K.; Nieger, M. Synthesis, esi and fab mass spectrometry, and x-ray analysis of di-and tricationic pyridinium substituted pyrimidines. Heterocycles 2002, 57, 615–621. [Google Scholar]
- Sasaki, I.; Daran, J.-C.; Commenges, G. The simple production of nonsymmetric quaterpyridines through kröhnke pyridine synthesis. Beilstein J. Org. Chem. 2015, 11, 1781–1785. [Google Scholar] [CrossRef] [PubMed]
- Grell, J.; Bernstein, J.; Tinhofer, G. Graph-set analysis of hydrogen-bond patterns: Some mathematical concepts. Acta Crystallogr. Sect. B Struct. Sci. 1999, 55, 1030–1043. [Google Scholar] [CrossRef]
- Bernstein, J.; Davis, R.E.; Shimoni, L.; Chang, N.L. Patterns in hydrogen bonding: Functionality and graph set analysis in crystals. Angew. Chem. Int. Ed. Engl. 1995, 34, 1555–1573. [Google Scholar] [CrossRef]
- Tetko, I.V.; Gasteiger, J.; Todeschini, R.; Mauri, A.; Livingstone, D.; Ertl, P.; Palyulin, V.A.; Radchenko, E.V.; Zefirov, N.S.; Makarenko, A.S.; et al. Virtual computational chemistry laboratory–design and description. J. Comput.-Aided Mol. Des. 2005, 19, 453–463. [Google Scholar] [CrossRef] [PubMed]
- Rueden, C.T.; Schindelin, J.; Hiner, M.C.; DeZonia, B.E.; Walter, A.E.; Arena, E.T.; Eliceiri, K.W. Imagej2: Imagej for the next generation of scientific image data. Bmc Bioinform. 2017, 18, 1–26. [Google Scholar] [CrossRef] [PubMed]

© 2020 by the authors. Licensee MDPI, Basel, Switzerland. This article is an open access article distributed under the terms and conditions of the Creative Commons Attribution (CC BY) license (http://creativecommons.org/licenses/by/4.0/).
Share and Cite
Rusew, R.; Kurteva, V.; Shivachev, B. Novel Quaternary Ammonium Derivatives of 4-Pyrrolidino Pyridine: Synthesis, Structural, Thermal, and Antibacterial Studies. Crystals 2020, 10, 339. https://doi.org/10.3390/cryst10050339
Rusew R, Kurteva V, Shivachev B. Novel Quaternary Ammonium Derivatives of 4-Pyrrolidino Pyridine: Synthesis, Structural, Thermal, and Antibacterial Studies. Crystals. 2020; 10(5):339. https://doi.org/10.3390/cryst10050339
Chicago/Turabian StyleRusew, Rusi, Vanya Kurteva, and Boris Shivachev. 2020. "Novel Quaternary Ammonium Derivatives of 4-Pyrrolidino Pyridine: Synthesis, Structural, Thermal, and Antibacterial Studies" Crystals 10, no. 5: 339. https://doi.org/10.3390/cryst10050339
APA StyleRusew, R., Kurteva, V., & Shivachev, B. (2020). Novel Quaternary Ammonium Derivatives of 4-Pyrrolidino Pyridine: Synthesis, Structural, Thermal, and Antibacterial Studies. Crystals, 10(5), 339. https://doi.org/10.3390/cryst10050339

